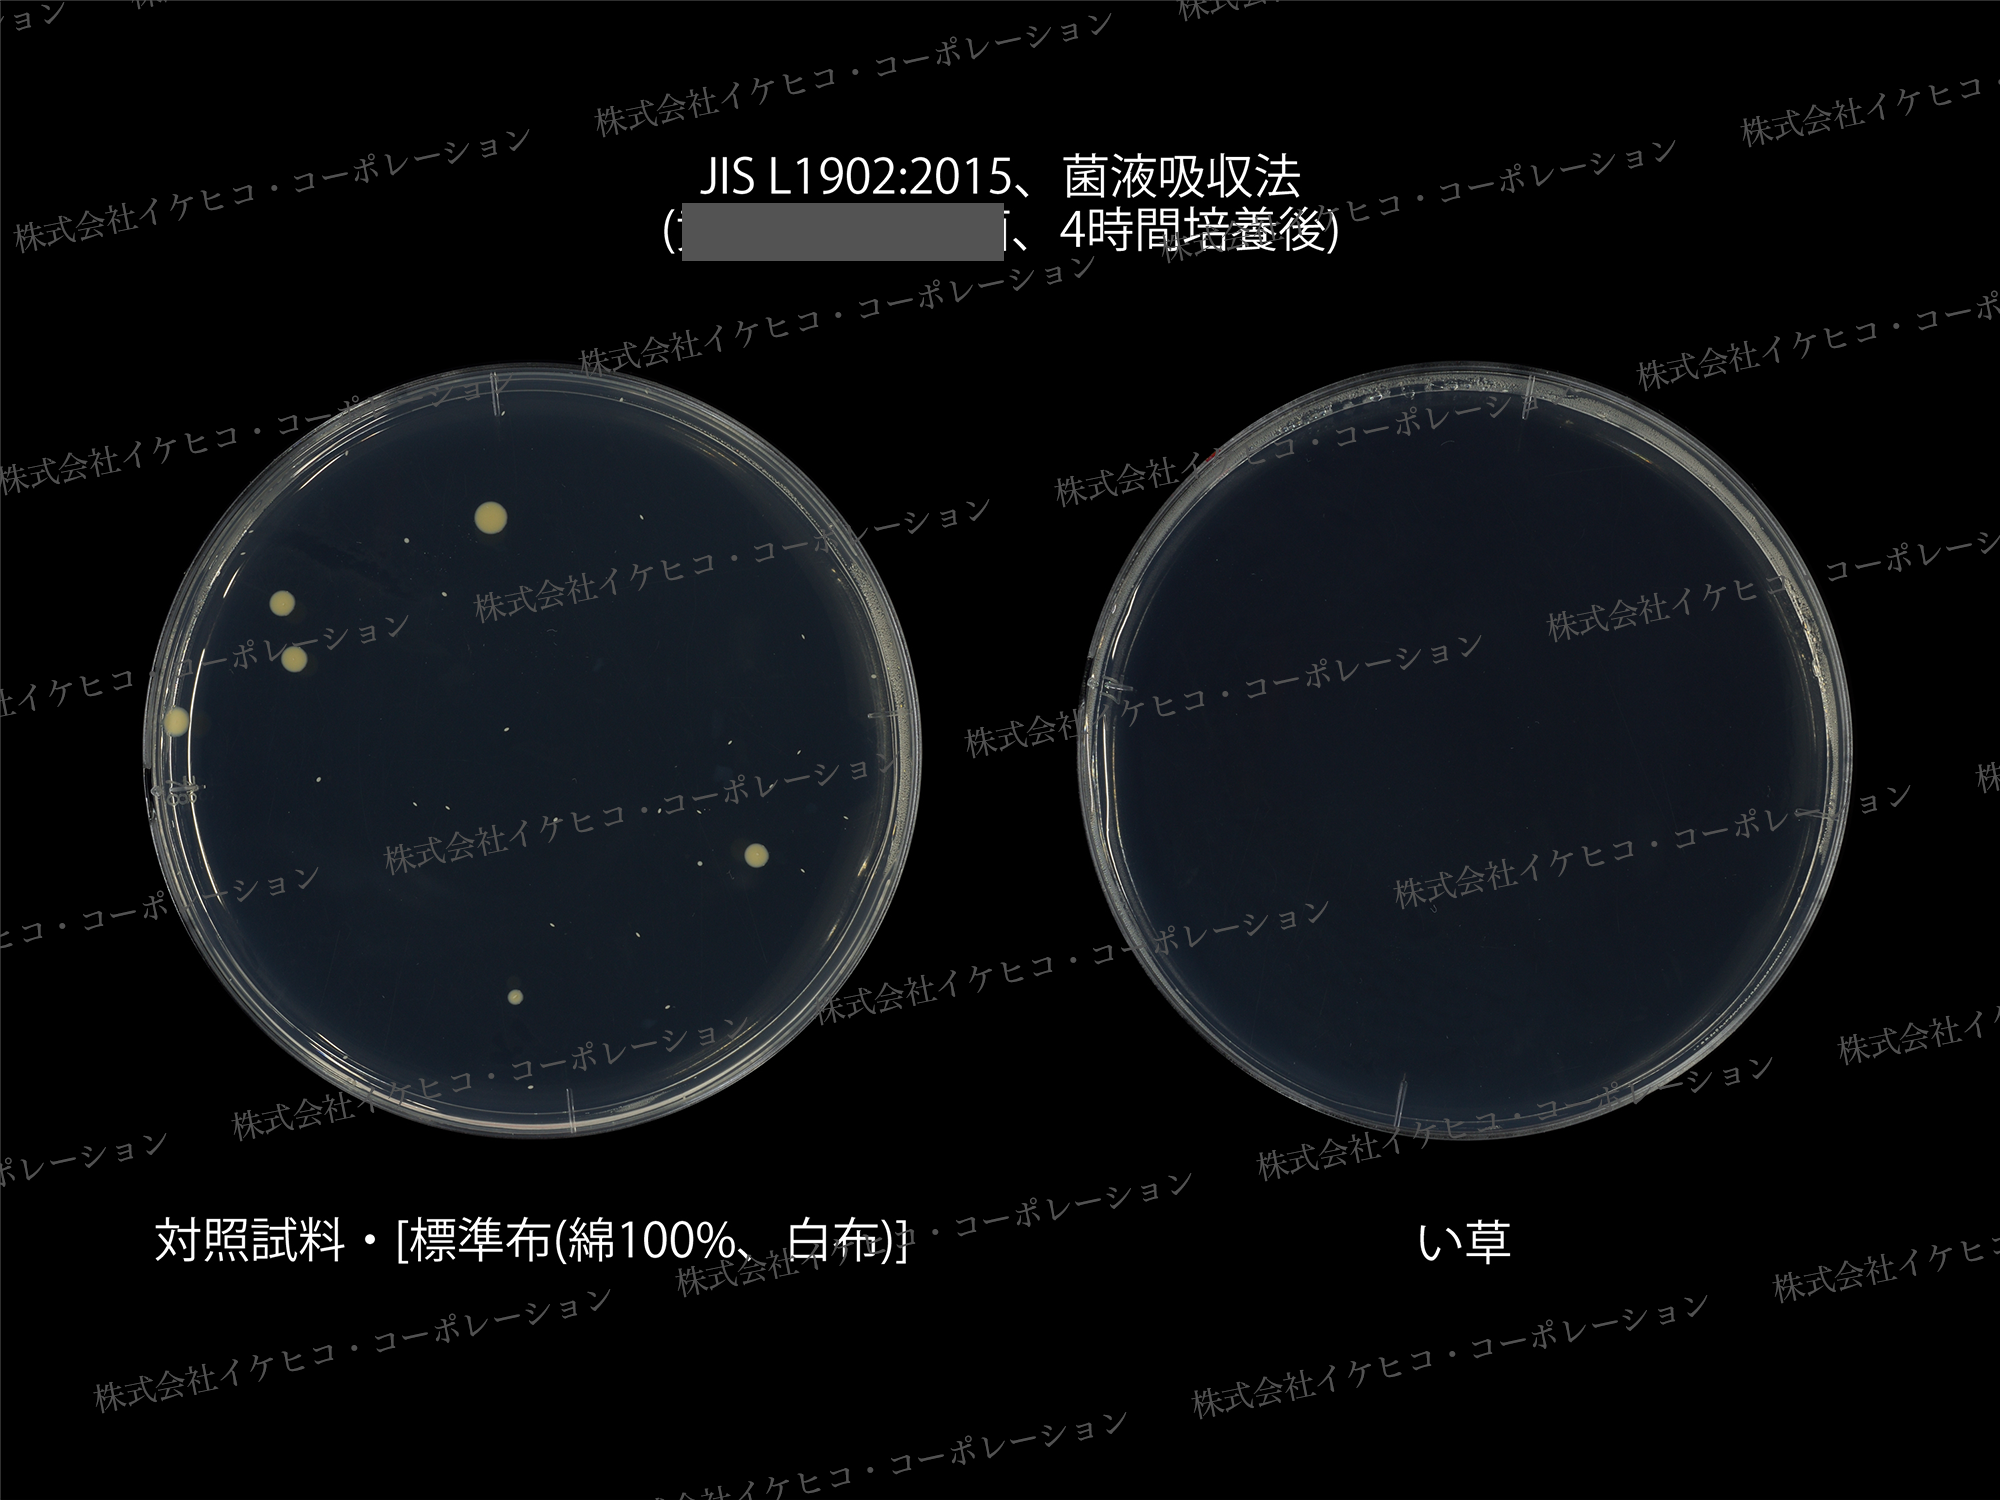

目標達成率 : 151%
10人
終了
このプロジェクトを一言で言うと?
い草の香りでぐっすり
国産い草で快眠を!秋冬の寝汗もべたつかず、洗濯不要で快適
\い草は夏だけじゃない!!/理想の睡眠環境を実現【国産い草の敷パッド】
プロジェクトについて質問やリターンに関する要望などを投稿することが出来ます。

私たちは創業138年の福岡にあるインテリアメーカーです。
この度、国産の無垢い草(畳の原材料である植物)を100%使用した、こだわりのインテリア「ミラクルシリーズ」第2弾をスタートいたします。

国産無垢い草のチカラで、暮らしに快適をお届けすべくスタートしたこのプロジェクト。
前回たくさんの方に応援いただきました。本当にありがとうございます。
第2弾となる今回は、新感覚の畳敷パッドが・・・!


畳に包まれるような優しい寝心地…。
そして、畳の原材料である自然素材い草の効果により「寝汗のかく夜を快適な睡眠環境へと整える」「洗わなくても清潔を保てる」寝具です。

ベッドでも敷布団でも今お使いの寝具に敷くだけでお使いいただけます。
更に、フローリングに直に敷いてもご使用いただけます。お気に入りの場所でお昼寝にも。











通常の泥染め加工を行ったい草とは違い、素材のままの無垢ない草を使用しています。全て自社栽培のい草です。粉っぽさも埃っぽさもなく、すべすべとした肌触りが特長。気持ちいい肌心地が、心地よい眠りへと誘います。

また、い草の調湿効果で、寝汗でベタベタしやすい夜も朝まで快適に過ごすことができます。
Tシャツやシーツが就寝中にかく汗で湿って気持ち悪い…毎日寝具を洗濯するのも大変…という方にもおススメです。

朝起きた時も、カラダや髪が湿気でベタベタせず、サラサラ~!な点にも感動いただけると思います。
朝シャワー要らずの爽やかさを体感いただけると幸いです。

昔からよくある寝ござは、1層構造で耐久性と硬さに課題がありました。
このミラクル敷きパッドは、細かな織り+こだわりの横つなぎ設計で、その課題を解消!

細かい織りを表現できる織機を使用し、2層構造で織っているため、耐久性も高く、畳に包まれているかのような柔らかさとなっています。

裏地に厚さ約3mmの不織布を採用したことで、従来の柔らかさはそのままに耐久性とクッション性が格段にアップしています。

フローリングに直に敷いても痛くないので、リビングなどお好きな場所でお昼寝にも最適です。


1層構造の従来品は、体に対してイ草の向きが垂直なため、サイドが反ったり、寝返りでずれたりします。

しかし、ミラクル敷きパッドは体とイ草の向きが同じになるように作っているため、ソリも少なく、寝姿勢に馴染みます。


裏地は滑り止めも備わっているので、とってもズレにくくなっています。ご覧の通り、同じ力加減でも、くしゃっとしません。

どんなに寝相が悪くても畳の上!ぐちゃぐちゃにならない敷きパッドは、ベッドメイキングも楽チン。

さらに今回、畳部分を広くするため、つなぎ目の布部分を細くしました。
畳の良さを全身でたっぷり感じていただきたいです。もちろん強度は変わらず。

四隅にはゴムバンドも付属。このゴムバンドは、厚みのあるマットレス(~約36cm)にも対応しています。ゴムバンド無しでもズレないので、お好みでお使いください。


日々の睡眠時に気になる汗のニオイや皮脂のニオイ。
畳の原材料であるイ草は、高い抗菌防臭や消臭効果もあるので、さまざまな気になるニオイを吸着分解してくれます!
ニオイの元となる雑菌が増えない自然素材のイ草。洗わなくても臭いません。
い草畳のある和室が年を経ても変なニオイがしないのと一緒です。まさに先人の知恵ですね。


抗菌防臭効果で臭わない、それだけではありません。
無垢のい草は、非常に高い防汚性を備えているため、洗わなくても清潔なんです!

お洗濯の手間がないので、水道代の節約や家事ラクに繋がります。
お手入れはカンタン!天気の良い日に陰干しするだけ!


サポーターさまのご要望にお応えすべく、クイーンやキングサイズまで作りました。
全5サイズ展開となっております。画像はクイーンサイズを使用しています。
大きいサイズまで製造できるのは、このミラクル敷きパッドの横つなぎ設計ならでは。
ご家族みんなで快適な夜をお過ごしください。





※全サイズ、表地は国産無垢い草100%の畳、裏地は全面不織布を使用しています。商品特性上、新しいうちは特有のにおいがします。気になる場合は天気の良い日に陰干ししてからお使いください。

サポーターの皆さま、初めまして。
開発者の田嶋と申します。
い草寝具をメインに製品開発を行っています。

い草という素材には、肌が触れ合う瞬間のさらさら感、思わず頬擦りしたくなるような心地良さがあります。

さらに、自然素材でありながらもたくさんの機能性があり、日本の夏を涼しく暮らすのにぴったりの素材です。

古来から紡がれてきた畳という先人の知恵は、令和の現代でも、快適な時間を過ごす手助けになると考えています。

い草に癒されながら、より快適な睡眠をサポートしたいという思いで、今回の製品をお届けいたします。

就寝中や朝起きた時のサラサラ感はもちろんですが、お風呂上りカラダを拭いた後に、ごろんと寝転んでみてください。格別な気持ち良さがそこにはあります。ぜひ一度ご体感いただけると嬉しいです。


い草という素材を使用することで、い草と肌が触れ合う瞬間のさらさら感、思わず頬擦りしたくなるような心地良さが快適な時間を過ごす手助けになると考えています。ライフスタイルの変化と共に目にする機会がめっきり減ってしまった、日本の伝統床材の畳。畳の原材料であるい草は、なんと1,400年もの歴史があり、絶えることなく消えることなく、現役で使われ続けている奇跡的な自然素材です。薬品を使わず素材のままに、抗菌防臭・消臭・調湿・防汚など多くの機能が備わっています。


- 抗菌防臭効果
- 消臭効果
- 非常に高い防汚性
- 温度調整力
- 空気の悪い物質も吸着除去
- まるで森林浴のような良い香り
- 防火性も高く、燃えにくい


い草はニオイ菌をはじめとした菌の増殖を抑制します。ニオイの元が増えないので防臭効果も◎。薬品を使わず素材のままで、この効果!ミラクルな自然素材、い草です。
▲ 雑菌を培養して4時間経過のシャーレ
▲ 雑菌を培養して18時間経過のシャーレ
菌がじわじわと増えている布シャーレに対し、い草シャーレは菌が増えていません。
高い抗菌効果がうかがえます。

嫌な生活臭の原因物質(アンモニア・酢酸・イソ吉草酸・インドール・トリメチルアミン・ノネナール・ビリジンなど)を吸着して減少させ、悪臭を軽減します。気になる寝汗のニオイや皮脂のニオイも消臭します!
さらに、この消臭パワーは20年経っても変わりません!



い草は非常に高い吸湿性を備え、乾燥時には蓄えた水分を室内に放出する特性を備えています。上に示した表からも、い草の優れた湿度調整機能がわかります。これが、朝起きても寝汗でベタつかずサラサラな理由です!

い草は表面に油分を持っているので、非常に汚れにくい性質があります。
判定4級以上で防汚性が表示できる繊維の試験でなんと等級5の判定です!


汚染用グレースケール評価判定4級以上で防汚性表示ができる


い草の内部は六角形が重なったハチの巣のような構造で、その繊維と繊維の間には節があり、たくさんの小部屋を作っています。内部の表面積が広くスポンジ状になったい草が呼吸することで、空気中の二酸化窒素(HO2)やホルムアルデヒドを吸着にしてくれます。


どこか懐かしく感じるイ草の香り。なぜだかホッとして、心も休まる…。個人差はありますが、畳のお部屋に入ると、あーいい匂いだなあと深呼吸したくなる方も多いのではないでしょうか。

これは畳の原材料であるイ草に、バニラの香り成分であるバニリンや、森林の香りであるフィトンチッドという芳香成分が含まれているからなんです。日々の疲れをとる睡眠の時間も、ほんのり良い香りが漂って、癒されながら夢の中へ…。


なんとい草は自然素材なのに、防火性も高く、燃えにくいという性質も持ち合わせています。蚊取り線香を直にのせてもご覧の通り、燃え広がりません。


い草製品の製造&販売を通じて、い草の栽培を増加させることで、CO2を削減(13:気候変動に具体的な対策を)し、持続可能な生産消費形態(12:つくる責任つかう責任)に貢献します。また、い草のニーズを増やしていくことで生産に携わる皆さまの待遇改善(8:働きがいも経済成長も)にも導いていきます。

畳や和室自体があるご家庭の方が少ない昨今。畳がイ草でできていることを知らない方も多いと思います。平成16年には1,260戸あったい草農家さんも令和4年には、約314戸と大幅に減少してしまいました。どうか皆さんに、この国産の高品質ない草を使ったインテリアを通じて、昔ながらの畳の良さ、い草の良さを感じていただけたら嬉しいです。

【サイズ】
・シングル(約95×195cm)
・セミダブル(約115×195cm)
・ダブル(約135×195cm)
・クイーン(約155×195cm)
・キング(約175×195cm)
【原産国】
・日本
【組成】
・表地:い草(国産無染土い草)
・裏地:ポリエステル100% (不織布)
*裏面四隅ゴムバンド付き

Q:日ごろのお手入れはどうしたらいいですか?
A:い草商品を使用する場所は風通しの良い場所で、天気の良い日には窓を開けて常に換気を心掛けてください。お掃除は、い草の織り目に沿ってゴミを掃き出すか、掃除機をかけてください。週に1~2回、天気の良い日に日陰干しでカビの発生防止を行ってください。
Q:波打ちやシワが目立ちます。波打ちやシワは消えるのでしょうか?
A:はい、お使いになるうちにこれらのシワや波打ちは馴染みます。商品は流通上、折りたたんでいますので、お買い上げ・ご使用初めは多少の折りジワがあり、波打ったように見えることがあります。お使いになるうちにこれらのシワや波打ちは馴染みます。
Q:独特のにおいが気になります。
A:製品の特性上、新しいうちは特有のにおいがします。気になる場合は天気の良い日に陰干ししてからお使いください。
Q:一部のい草に黒くなっているものが見られるんですけど…
A:い草は自然素材ですので、一本、一本に色差があります。商品は天然のい草を製品化したものなので、問題はありません。

2025年10月14日(火)19時 プロジェクト開始
▼
2025年11月21日(金)18時 プロジェクト終了
▼
2025年12月末中のお届け予定です。

今回のリターンは、シングル(約95×195cm) / セミダブル(約115×195cm) / ダブル(約135×195cm) / クイーン(約155×195cm) / キング(約175×195cm)の5サイズ展開です。
少数のリターンもございますので、お早めにお願いいたします。




私たちイケヒコ・コーポレーションは、創業明治十九年(1886年)の、い草製品、ラグマット、カーペットをはじめとしたインテリアメーカーです。「こまかばってん大木町」がキャッチフレーズの福岡県の小さな町にあります。
い草栽培の一大産地である九州を拠点に、日本全国へ商品をお届けしています。い草の良さ、畳の良さを、次世代や世界へ伝えたいという想いで、ワークショップや農業体験など、さまざまなイベントも行っています。
国産無垢い草のインテリアーミラクルシリーズー
\洗濯不要!/拭くだけ簡単【国産い草のキッチンマット】|わくたん (wakutan)
リスク&チャレンジ
・製品の特性上、新しいうちは特有のにおいがします。気になる場合は天気の良い日に陰干ししてからお使いください。
・製品の仕様は、一部変更になる可能性もございます。またい草は自然素材ですので、色や形状のバラつき、サイズ誤差などがあります。
・ご注文状況、使用部材の供給状況、製造工程上の都合等により出荷時期が遅れる場合があります。
・使用感などに関しては、感じ方に個人差が予想される製品でございます。そのため、使用感等に関する返品返金はお受けいたしかねます。
・雨の日などで濡れた場合は、カビの原因になりますので、風通しの良い場所で陰干ししてください。
※原則として、配送遅延に伴う購入のキャンセルはできませんが、リターン配送予定月から1ヶ月を超えた場合には、希望者に限りキャンセルさせていただきます。










